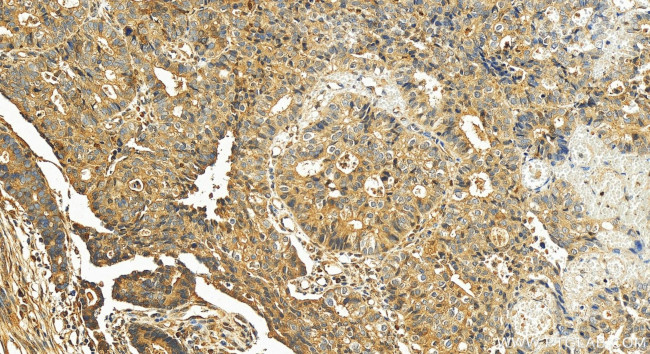
MATN3 Antibody in Immunohistochemistry (Paraffin) (IHC (P))

Search
Proteintech
MATN3 Polyclonal Antibody
{{$productOrderCtrl.translations['antibody.pdp.commerceCard.promotion.promotions']}}
{{$productOrderCtrl.translations['antibody.pdp.commerceCard.promotion.viewpromo']}}
{{$productOrderCtrl.translations['antibody.pdp.commerceCard.promotion.promocode']}}: {{promo.promoCode}} {{promo.promoTitle}} {{promo.promoDescription}}. {{$productOrderCtrl.translations['antibody.pdp.commerceCard.promotion.learnmore']}}
产品信息
25500-1-AP
种属反应
宿主/亚型
分类
类型
抗原
偶联物
形式
浓度
规格
纯化类型
保存液
内含物
保存条件
运输条件
产品详细信息
Immunogen sequence: SRFQETFCAL DPCVLGTHQC QHVCISDGEG KHHCECSQGY TLNADKKTCS ALDRCALNTH GCEHICVNDR SGSYHCECYE GYTLNEDRKT CSAQDKCALG THGCQHICVN DRTGSHHCEC YEGYTLNAD
靶标信息
Matrilins (MATNs) are a family of non-collagenous extra-cellular matrix (ECM) proteins consisting of four known members that have been proposed to play key roles in modulating cellular phenotypes during chondrogenesis of mesenchymal stem cells (MSCs). MATN1 and MATN3 are expressed specifically in cartilage and are among the most up-regulated ECM proteins during chondrogenesis. MATN3 is composed of a single N-terminal von Willebrand Factor A (vWFA) domain followed by four epidermal growth factor (EGF) repeats and a coiled-coil domain whereas MATN1 is composed of two vWFA domains separated by one EGF-like domain. MATN1 or MATN3 may play a role in modulating chondrogenesis during the chondrocyte differentiation process. Mutations of this gene have been associated with variety of inherited chondrodysplasias. Recent studies show that aberrant expression and processing of MATN3 are hallmarks of conventional cartilaginous neoplasms.
仅用于科研。不用于诊断过程。未经明确授权不得转售。
篇参考文献 (0)
生物信息学
蛋白别名: B14.5b; CI-B14.5b; Matrilin-3; matrilin-3 lacking EGF-1 domain; NADHDH2; NDUFC2; unnamed protein product
基因别名: DIPOA; EDM5; HOA; MATN3; OADIP; OS2; SEMDBCD
UniProt ID: (Human) O15232
Entrez Gene ID: (Human) 4148